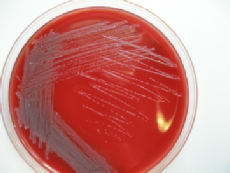

Equine Science Update
Reports from the world of equine research.
Researchers in Denmark have identified a new cause of respiratory disease in horses. They found the bacterium Stenotrophomonas maltophilia in samples collected from horses with chronic lower airway disease.
Written by Mark Andrews. Published online 24.02.10
© Copyright Equine Science Update 2010
© Copyright Equine Science Update 2010
New equine respiratory condition described
| Sign up for our FREE e-mail newsletter. |
Stenotrophomonas maltophilia, a Gram-negative bacterium, has been found increasingly in human medicine, especially in patients with impaired immune systems. Until recently the organism has been recorded only rarely in animals.
According to the researchers “this pathogen has not previously been associated with lower airway disease in the horse.”
In a paper to be published in the Veterinary Journal, Lotte Winther, a PhD student in the Department of Large Animal Sciences at the University of Copenhagen, and colleagues present data from seven horses with respiratory disease associated with S. maltophilia infection. The horses were treated at three equine referral hospitals in Denmark in 2007.
The report documents the clinical findings, laboratory diagnosis and response to treatment.
All cases had a history of chronic coughing. Endoscopic examination revealed copious mucopurulent exudate in the lower trachea. Culture of the tracheal exudate produced grey, slow-growing colonies, which were identified as S. maltophilia by both culture and DNA testing.
All isolates had a similar antibiotic susceptibility pattern. They were resistant to many antibiotics used to treat respiratory infections in horses, including all penicillins, cephalosporins, aminoglycosides and rifampicin.
"The results from susceptibility testing and clinical response to treatment suggest prolonged administration of tetracyclines (greater than 10 to 14 days) is an effective treatment, especially for adult horses," advise the researchers.
The findings suggest that S. maltophilia can act as a respiratory pathogen. The researchers advise that the organism be included in the differential diagnosis of horses with respiratory disease associated with copious mucopurulent exudate.
They stress that many antibiotics commonly used to treat equine respiratory infections are not effective against S. maltophilia.
For more details see:
Association of Stenotrophomonas maltophilia infection with lower airway disease in the horse: A retrospective case series.
Winther L, Andersen RM, Baptiste KE, Aalbæk B, Guardabassi L.
Vet J. 2009 Sep 14.
http://dx.doi.org/10.1016/j.tvjl.2009.08.026
According to the researchers “this pathogen has not previously been associated with lower airway disease in the horse.”
In a paper to be published in the Veterinary Journal, Lotte Winther, a PhD student in the Department of Large Animal Sciences at the University of Copenhagen, and colleagues present data from seven horses with respiratory disease associated with S. maltophilia infection. The horses were treated at three equine referral hospitals in Denmark in 2007.
The report documents the clinical findings, laboratory diagnosis and response to treatment.
All cases had a history of chronic coughing. Endoscopic examination revealed copious mucopurulent exudate in the lower trachea. Culture of the tracheal exudate produced grey, slow-
All isolates had a similar antibiotic susceptibility pattern. They were resistant to many antibiotics used to treat respiratory infections in horses, including all penicillins, cephalosporins, aminoglycosides and rifampicin.
"The results from susceptibility testing and clinical response to treatment suggest prolonged administration of tetracyclines (greater than 10 to 14 days) is an effective treatment, especially for adult horses," advise the researchers.
The findings suggest that S. maltophilia can act as a respiratory pathogen. The researchers advise that the organism be included in the differential diagnosis of horses with respiratory disease associated with copious mucopurulent exudate.
They stress that many antibiotics commonly used to treat equine respiratory infections are not effective against S. maltophilia.
For more details see:
Association of Stenotrophomonas maltophilia infection with lower airway disease in the horse: A retrospective case series.
Winther L, Andersen RM, Baptiste KE, Aalbæk B, Guardabassi L.
Vet J. 2009 Sep 14.
http://dx.doi.org/10.1016/j.tvjl.2009.08.026
S. Maltophilia produces grey slow-growing colonies.
Photo courtesy Dr Lotte Winther.